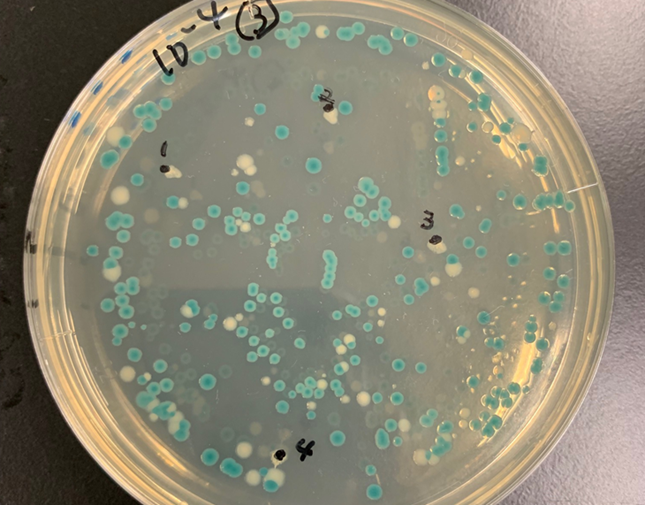

公開講座「遺伝子工学実習講座 DNAコース」を開催
2025年10月23日
9月11日(木)から12日(金)に、府中キャンパス学術研究支援総合センター 遺伝子実験施設において「遺伝子工学実習講座 DNAコース」が開催されました。
本講座は初心者を対象に講義と実習をとおして遺伝子工学の基礎を学ぶことを目的としており、タンパク質コースと交互に隔年開講しています。社会人対象のリカレント教育の場として高い評価を得ており、今回は民間企業の機器担当者、公的研究機関の研究員、他大学の大学院生・研究員など,全国から5名が参加しました。
実習では、遺伝子実験施設専任教員の指導のもと、大腸菌コロニーの観察、PCR法、形質転換、菌の培養、プラスミドDNAの単離、制限酵素処理、アガロースゲル電気泳動など、遺伝子工学における基本的な実験操作を体験しました。さらに、ラムダファージのゲノムライブラリーを用いた実験では、各自が寒天培地に形成された大腸菌のコロニーを選び、その中のプラスミドがラムダファージゲノムのどの部分のDNA断片を保持しているかを特定する作業を行いました。
受講者の動機はさまざまで、未経験分野に挑戦して少しでも知識を深めたい方、研究に役立てるために実践的な技術を習得したい方、遺伝子工学の基礎技術を身につける最適な場を求めていた方、未来の農業や生命科学を担う人材育成の第一歩としたい方などが参加されました。
本講座で得られた知識と技術が、今後それぞれの職場や研究活動に活かされることが期待されます。